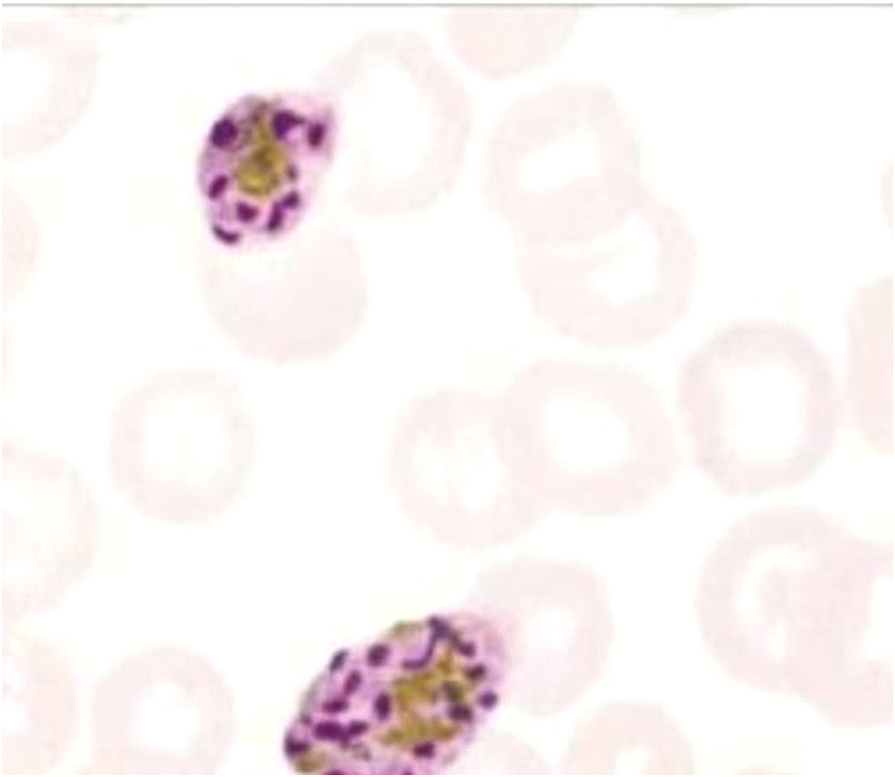
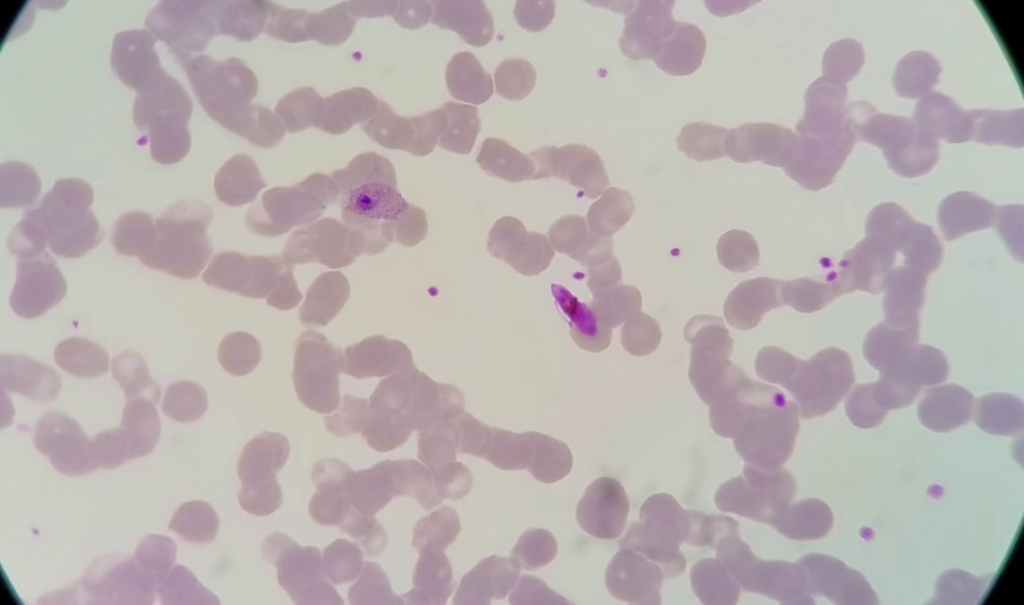

Plasmodium ovale is a species of malaria first described in 1914 by Stephens from a blood sample taken from a patient in Pachmarhi, Madhya Pradesh, India, during the autumn of 1913. It was initially confused with P. vivax (Pv) due to its tertian fever pattern (temperature returns every 48 hours) and morphological similarity.
It was later confirmed as a distinct species discovered by Stevens in the year 1922 in the blood of a soldier from South Africa. In 1922, Stephens observed its unique characteristic of oval-shaped, fimbriated erythrocytes in patients from Africa.
Genetic Species and Transmission
Genetic studies of P. ovale have identified two distinct species:
- P.o. curtisi
- P.o. wallikeri
These are named in honor of Christor Curtisi and David Wallikeri.
P. ovale is transmitted by the Anopheles mosquito. In both P. ovale (Po) and P. vivax (Pv), the parasites primarily infect reticulocytes (young RBCs), which are larger than normal RBCs, causing the infected RBCs to become enlarged.
Stages of Plasmodium Ovale
The following stages are found in P. ovale:

Ring Stage
- Rings are thicker than those of P. vivax and have a more compact appearance.
- The infected RBC is often oval or fimbriated (having irregular edges).
Trophozoite Stage
- Trophozoites are larger and more irregularly shaped.
- They have sturdy cytoplasm and larger chromatin dots.
- Schuffner’s dots (fine red granulation) are present in the cytoplasm of the infected RBC.
- Trophozoites become enlarged and oval with irregular margins.
- P. Vivax trophozoites are often ameboid and larger with prominent cytoplasm, while P. ovale tends to be compact with less vacuolation.
Schizont Stage
- Mature schizonts contain 4 to 16 merozoites clustered around dark brown pigment.
Gametocyte Stage
- Gametocytes are round to oval in shape.

Plasmodium ovale-gametocyte+Plasmodium Falciparum (mix-infection)
